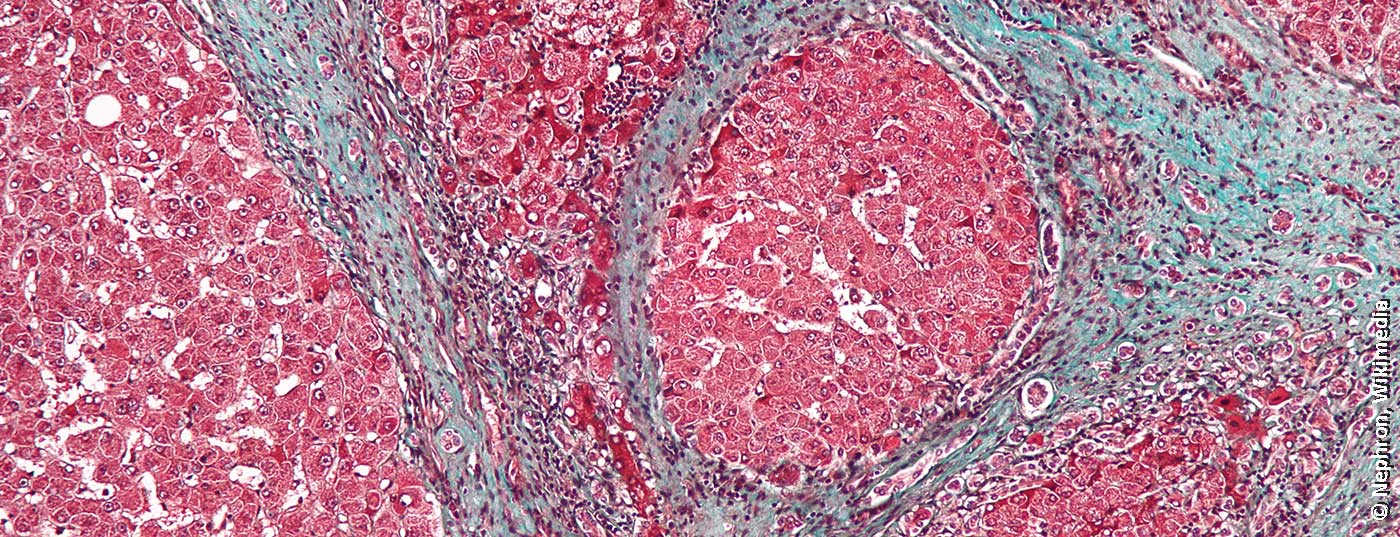
leberzirrhose

Durch die aktuell auf dem Markt verfügbaren hochwirksamen Virostatika sind die Heilungschancen sehr hoch. Unbehandelt kann eine Hepatitis-C-Infektion jedoch folgenschwer verlaufen. Das von Hepatitis Schweiz lancierte Projekt HepCare bietet Hausärzten Unterstützung zur Durchführung der neuen direkt antiviralen Therapien und sensibilisiert für die hohe Rate undiagnostizierter Fälle.